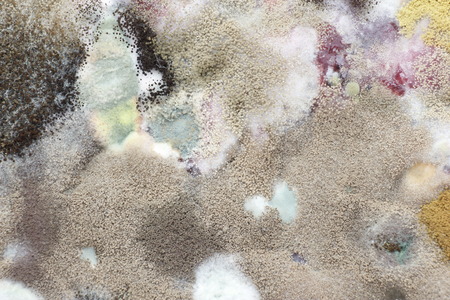
Moldyの写真素材

写真素材 - Moldy
キーワード
- abstract
- agar
- agar agar
- background
- bacteria
- bacterium
- biological
- biology
- biotechnology
- cells
- circular
- closeup
- colony
- culture
- decayed
- filamentous
- fungi
- fungus
- fuzzy
- germs
- green
- growing
- infection
- lab
- laboratory
- life
- macro
- messy
- micro
- microbes
- microbial
- microbiology
- microorganism
- mildew
- moldy
- mould
- mouldy
- nobody
- organism
- penicillium
- putrid
- putrid
- rancid
- research
- rotten
- round
- science
- scientific
- spores
- stinking
- study
- substance
- sullen
- technology
- tiny
- wry
- ecosystem
- mold
- organism
- particle
- rotten
- spoiled
類似作品
Close up of mol...
Mold close-up m...
fungal mildew o...
A piece of food...
Grunge wall. Us...
Backgrounds of ...
natural mold on...
Pumpkin covered...
Close up of mol...
mold on pickled...
A close up of a...
mold in orange ...
spread of green...
mold colonies
mold on eggplan...
Fungi culture o...
Mold
Shot of mold on...
Macro image of ...
Concept - expir...
Mold close-up m...
microbiology ba...
Yellow fungus ...
This image appe...
Mold on red
Designed grunge...
Mold and fungus...
Penicillium, as...
Mold on noodles...
macro of mold r...
Tiny Slime mold...
Coronavirus bac...
Mushroom cultiv...
Mold. Nice mold...
macro of mold r...
Pumpkin covered...
Close-up on tex...
green and white...
mildew in a can...
Growth of asper...
Macro detail of...
microbiology ba...
Tiny Slime mold...
Macro texture o...
green yellow ro...
Backgrounds of ...
Nasty blue-gree...
Artistic macro ...
Mold colonies o...